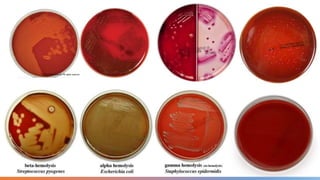
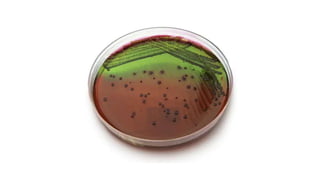
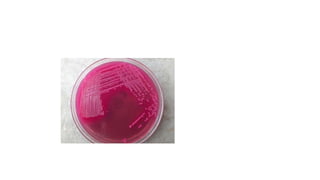
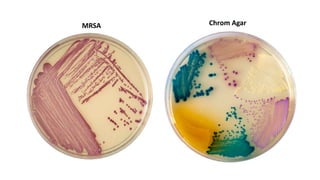
MRSA Chrom Agar

This document discusses cell nutrition and culture media. It notes that different organisms require different nutrients, with macronutrients needed in large amounts and micronutrients in trace amounts. Cells are made up primarily of macromolecules like proteins, nucleic acids, lipids, and polysaccharides. Culture media are used to grow microorganisms and can be defined, containing precise chemicals, or complex, containing digests of microbial, animal, or plant products. Selective and differential media are used to isolate specific microorganisms using indicators and inhibitors. Examples of commonly used media like EMB, MacConkey, MSA, TSI, and CHROM agar are described.